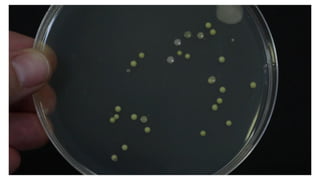

Embed presentation
Download to read offline






















This document provides information about the active ingredients in four common household products: bleach, detergent, dishwashing liquid, and toilet bowl cleaner. It includes a table to fill out with the active ingredients of each product. Students are asked to identify which product performed best and least, list the active ingredients of each, and explain why knowing the active ingredients is important.